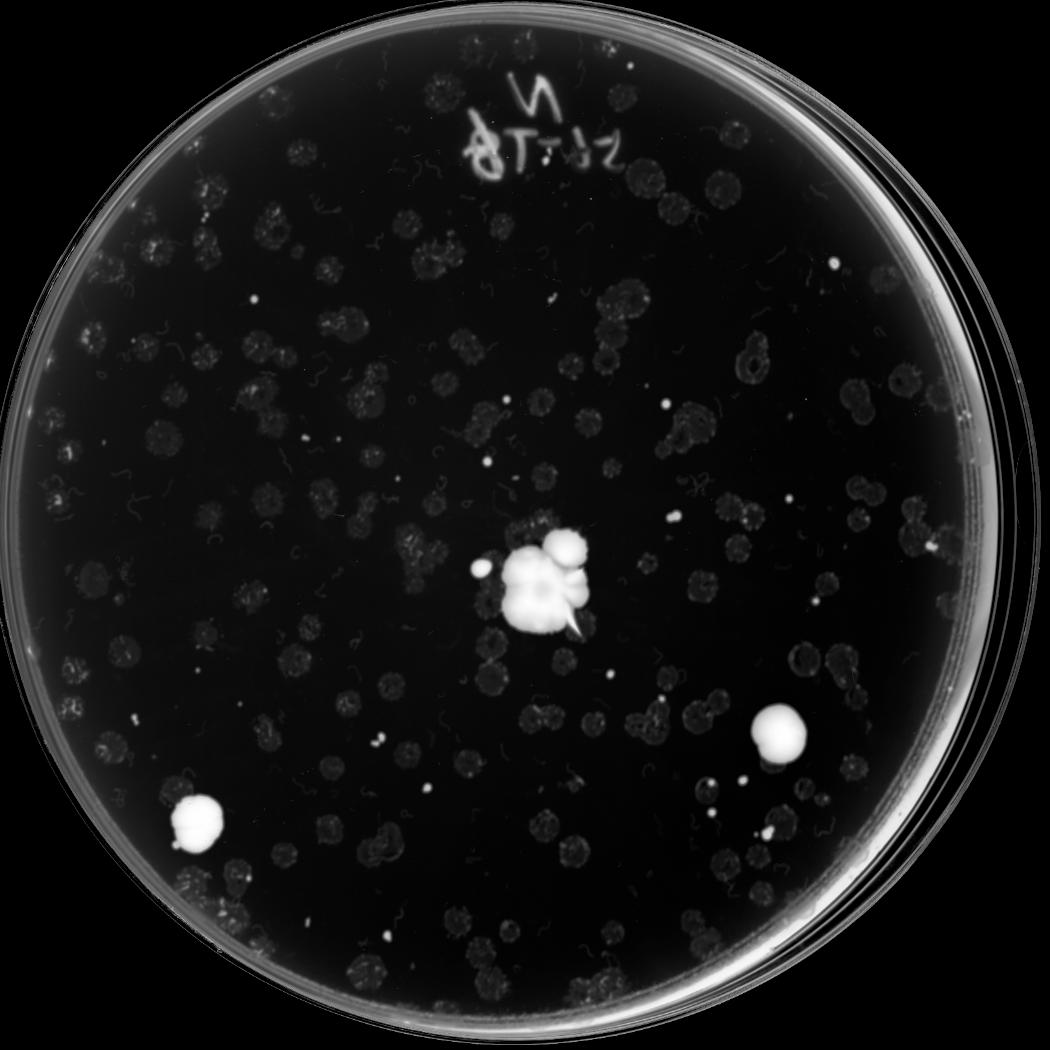

A

B

C

D
E

F

G

A: Candidate | No selection
B: Candidate | Selection for essential gene deletion (with long-time incubation)
C: Candidate | Selection for essential and suppressor genes double mutation (with long-time incubation)
D: Candidate | Selection for essential gene deletion (replicated from plates selecting for essential gene deletion)
E: Candidate | Selection for essential and suppressor genes double mutation (replicated from plates selecting for essential and suppressor genes double mutation)
F: Quantification | Illustration of the strain arrangement of the semi-quantification plate
G: Quantification | Quantification in restreaking format